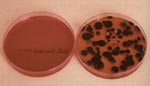

|
||||||||||||||||||||||||||||||||||||||||||||||||||||||||||||||||||||||||||||||||||||||||||||||||||||||||||||||||||||||||||||||||||||||||||||||||||||||||||||||||||||||||||||||||||||||||||||||||||||||||||||||||||||||||
| 1. Introducción
La forma de conocer la confianza en los tapones, antes de su utilización, se realiza por medio del control de calidad. La materia prima de partida (planchas de corcho), incide directamente en la calidad de los tapones, entendida inicialmente por medio de la evaluación de su aspecto externo. La evaluación de dicho aspecto toma carácter universal con la utilización de equipos de clasificación automática (Ver figura 4.12). Figura 4.12. Clasificadora automática de tapones basada en tratamiento de imágenes Figura 4.13. Clases de tapones cilíndricos de una pieza de corcho natural La automatización en el escogido de tapones animó a la presentación de propuestas de patrones para los tapones cilíndricos de una pieza de corcho natural. Algunas establecen la división en siete clases (Ver figura 4.13), sin que se hayan alcanzado acuerdos. La evaluación de la cabeza del tapón tiene un interés especial al ser la que está en contacto con el vino (Ver figura 4.14) Figura 4.14. Aspecto de las cabezas de tapones cilíndricos de una pieza de corcho natural Durante la fabricación de los tapones también se ven afectadas las propiedades del corcho. Tiempo de estabilización, pulido, secado, lavado y lubricado repercuten o inciden en la ovalación, humedad, higienización y fuerza de extracción respectivamente. Disponemos, por lo tanto, de dos factores determinantes de la calidad de nuestro producto, uno es la materia prima de partida y otro es el proceso de fabricación. Es necesario conocer las características que influyen en la calidad de los tapones, con el fin de evaluarlas y establecer los valores que deben tener para garantizar la confianza en el cumplimiento de su función. La comprobación de estas características podrá realizarlas el taponero en el momento de efectuar la expedición, el bodeguero a la recepción de los tapones, un laboratorio de ensayo, etc.; todos pueden evaluar las características, pero acordando previamente cuál deber ser el procedimiento a seguir, definiendo equipos, personal y métodos. Para poder dar validez a los resultados de los ensayos, todas las actuaciones deberán registrarse por escrito, así se podrá demostrar que fueron realizados conforme a los procedimientos acordados. Una de las formas de establecimiento de acuerdos lo constituyen las normas. En el caso de España se dispone de las normas UNE (Una Norma Española); para Portugal están las normas NP (Norma Portuguesa); para la Unión Europea son las EN (Europea Norma); internacionalmente tenemos las ISO (International Organization for Standardization), etc. 2. Muestreo.
El nivel de calidad es la exigencia que le pedimos a la muestra para aceptar la partida o lote. En la siguiente tabla, obtenida estadísticamente, se establecen diferentes niveles de calidad o exigencia aceptables según ISO 4707-1981.
Ejemplo: En un lote de 50.000 tapones al que le aplicaremos un nivel de calidad de 2,5, debemos tomar una muestra de 500 tapones y, de ellos, hasta 21 podrán tener las dimensiones fuera de tolerancias para aceptar el lote. Si hay 22 o más rechazaríamos el lote. Para facilitar los muestreos existen normas específicas que son aplicables a cualquier tipo de producto, en el caso de los tapones la norma referenciada es la UNE 66020-73. 3. Acondicionamiento de las muestras.
Las condiciones normales de estabilización de las muestras son: 65% (±5%) de humedad relativa, 20º C (±2º C) de temperatura. El equipo necesario es la denominada Cámara climática (Ver figura 4.15) Figura 4.15. Cámara climática para estabilizar las muestras 4. Ensayos.
a) Humedad. La humedad nos informa del contenido en agua de los tapones. Se expresa en porcentaje, referido a corcho húmedo. Cuando decimos que un corcho tiene un 6% de humedad significa que hay 6 Kilogramos de agua por cada 100 Kilogramos de corcho húmedo. La humedad afecta a las características de los tapones en la forma indicada a continuación:
Existen dos métodos para la determinación de la humedad: El método tradicional es más exacto y consiste en secar, mediante estufa, los tapones previamente pesados en balanza. El método rápido se basa en la medida de un parámetro eléctrico, la resistividad o resistencia al paso de la corriente eléctrica por unidad de longitud, que se modifica por el contenido de agua de los tapones. Mediante el método tradicional: o Estufa, capaz de mantener a 103T ±20º C la temperatura y provista de aire forzado (Ver figura 4.16) Figura 4.16. Estufa de secado con ventilación forzada Figura 4.17. Desecador Por el método rápido: o Equipo específico (Ver figura 4.18) Figura 4.18. Equipo para la determinación rápida de la humedad b) Masa. La masa es necesaria para determinar la densidad y la humedad, se expresa en gramos y se contempla como parámetro independiente en los tapones para vinos espumosos. El equipo para determinar la masa es: Balanza de 0.001 gr. de sensibilidad (0.01 gr. para tapones de vinos espumosos) (Ver figura 4.19). c) Dimensiones. Las dimensiones de los tapones, longitud y diámetro, se expresan en milímetros y se utilizan para identificarlos de la forma siguiente: Tapón 44x24. Es un tapón de 44 mm. de longitud nominal por 24 mm. de diámetro nominal. Para los tapones cilíndricos de una pieza de corcho natural el diámetro es la media aritmética de los diámetros, medidos en sentido paralelo y perpendicular a las líneas de crecimiento (Ver figura 2.20). El término nominal se refiere a cómo se nombran o nominan, las dimensiones reales se determinan en los ensayos y se comparan con las nominales para comprobar si están dentro de las tolerancias exigidas. Figura 4.19. Balanza de 0,001 gr. de sensibilidad Figura 4.20. Partes y diámetros de un tapón cilíndrico de una pieza de corcho natural Figura 4.21. Pie de rey digital de 0,01 mm. de sensibilidad El equipo para determinar las dimensiones es: o Pie de rey de 0.01 mm. de sensibilidad (Ver figura 4.2 1 ) Al ser el corcho un material que cede a la presión, resulta importante en la determinación de esta característica la presión ejercida. Hoy día existen en el mercado pies de rey de presión constante que eliminan este error de operario. Los comparadores ofrecen un resultado en la determinación de las dimensiones más preciso que los pies de rey, al eliminar el error de ortogonalidad entre eje del tapón (o entre su diámetro) y el palpador (Ver figura 4.22) Figura 4.22. Comparador digital de 0,01 mm. de sensibilidad e impresora d) Ovalación. Los tapones cilíndricos de una pieza de corcho natural tienen como peculiaridad su ovalación. La ovalación es la diferencia, en valor absoluto, del diámetro paralelo y perpendicular (Ver figura 4.20). Se expresa en milímetros. La obtención del tapón cilíndrico de una pieza de corcho natural con el sacabocado o gubia, que es cilíndrico, no afecta a la ovalación. No obstante, las tensiones del corcho durante su crecimiento pueden evidenciar este parámetro si no se ha conseguido equilibrarlas, ya sea por un hervido insuficiente o por una estabilización térmica-acuosa defectuosa. El equipo para su determinación es el mismo que el equipo dimensional. Ovalación = Abs (Dpa – Dpe) Donde: o Dpa es el diámetro medido en el sentido paralelo a las líneas de crecimiento. e) Densidad aparente. La densidad de los tapones viene dada por el cociente entre la masa del tapón y su volumen. La de los tapones cilíndricos, expresada en Kg/m3, viene dada por la fórmula: D = (M x 4 x 106) 1 ( &Mac185; x D2 x L) Donde: o D es la densidad en Kg/m3. Cuando exista dificultad en la obtención del volumen del tapón, porque está biselado o tiene una forma geométrica que dificulte su determinación (troncocónica etc.), podemos recurrir al Principio de Arquímedes para determinarlo directamente, mediante su inmersión en un líquido contenido en probeta graduada y realizando lectura directa en la escala. (Ver figura 4.23). Figura 4.23. Probeta guardada para la determinación directa del volumen La densidad de los tapones de una pieza de corcho natural varía con las características del corcho de acuerdo a lo que se indica en la siguiente tabla:
f) Capilaridad. La capilaridad es la propiedad del tapón para atraer al líquido que le moja y hacerlo ascender por su superficie hasta cierta altura (Ver figura 4.24). Se expresa en milímetros de altura que alcanza el líquido en la superficie del tapón, a partir del nivel de mojado, al cabo de 24 horas o del tiempo que se establezca en el procedimiento. La capilaridad puede verse afectada por diferentes factores según se recoge en la siguiente tabla:
Este ensayo requiere los medios siguientes: o Solución etanólica al 10% v/v, coloreada de rojo, o azul de metileno p.e. (utilizar siempre agua destilada, nunca agua de grifo directamente, pues ésta afecta a la tensión superficial). (Ver figura 4.24) La altura de mojado, 3 mm. según norma, nos ayudará a conocer el volumen de solución que debemos utilizar en función del diámetro del tapón y el recipiente que lo contendrá, el cual, si es cilíndrico, viene dado por: V = ( &Mac185; x 3/40) x (D2 – d2) Donde: o V es el volumen de solución etanólica en mililitros. Figura 4.24. Capilaridad. Soluciones etanólicas con colorante azul de metileno y rojo Figura 4.25. Capilaridad. Campana para evitar la evaporación de la solución etanólica g) Fuerza de extracción. La fuerza de extracción viene dada por la resistencia del tapón al descorche, medida en unas condiciones determinadas. Se expresa en decanewton (daN). 1 daN equivale a 1.02 Kgr-fuerza o Kilopondio. Las variables que entran en juego en este parámetro se indican en la tabla siguiente:
El equipo para realizar su determinación consta de: o Sacacorchos normalizado (Ver figura 4.26). Figura 4.26. Fuerza de extracción. Sacacorchos normalizado o Dinamómetro (Ver figura 4.27). Figura 4.27. Fuerza de extracción. Dinamómetro h) Recuperación diametral. La recuperación diametral, como su nombre indica, nos informa de la capacidad de retorno del tapón a su volumen inicial tras sufrir una compresión de su diámetro. Es la que permite que se adapte al interior del gollete de la botella para cumplir su función de tapamiento. La recuperación diametral viene dada por el cociente entre el diámetro del tapón, medido tras la compresión, y el diámetro inicial previo a la compresión, expresando el resultado en porcentaje. Es aconsejable realizar una marca o raya, en la zona del costado donde se efectúa la medida del diámetro, para que sirva de referencia en las determinaciones siguientes. El equipo necesario para el ensayo consta de: o Pie de rey o comparador que permita medir el diámetro con 0.01 mm. de sensibilidad (Ver figuras 4.21 y 4.22). Figura 4.28. Encorchadora de compresión con 4 mandíbulas móviles i) Contenido en polvo. El contenido en polvo es la masa de partículas separables de los tapones durante el ensayo. Se expresa en miligramos de polvo por tapón. En los tapones colmatados, esta característica nos informa sobre la fragilidad de la unión de las partículas de polvo que colmatan los poros. En los tapones aglomerados, el resultado da una idea de cuál ha sido el nivel de polvo-ambiente existente en las últimas etapas de terminación. Los resultados del ensayo se ven muy influenciados por el grado de agitación al que se someten los tapones en la solución de extracción, por lo que debe estar bien definido. La estabilización del filtro, antes de su uso y después de retener el polvo, es otro punto crítico dado el nivel de sensibilidad que se exige. El equipo necesario para determinar el contenido en polvo de los tapones es: o Balanza analítica. Sensibilidad 0.0001 gr. (Ver figura 4.29) Para determinar los posibles errores durante el ensayo es necesario efectuar paralelamente un ensayo en blanco (Ver figura 4.30) Figura 4.29. Autoclave para esterilización Figura 4.30. Filtros del ensayo de polvo. Ensayo en blanco y con tapones j) Análisis microbiológico. El análisis microbiológico nos informa del grado higiénico de los tapones. Para evitar un incremento del nivel microbiano en las muestras de ensayo, deben mantenerse en condiciones que eviten su contaminación y/o proliferación. Esto se consigue mediante utilización de materiales estériles y ambientes con temperaturas bajas. El análisis se efectúa para bacterias, hongos filamentosos y levaduras. También se contemplan, en algunos casos, los lactobacillus y streptomices. Deben realizarse ensayos paralelos en blanco, es decir, con la solución de extracción exclusivamente, siguiendo todos los pasos para que se garantice que no existe contaminación cruzada. Los resultados se dan en UFC (Unidades Formadoras de Colonias) por tapón. Los específicos de streptomices y lactobacillus con ausencia o presencia. El equipo para la determinación microbiológica consta de: o Autoclave (Ver figura 4.31). Figura 4.31. Balanza analítica de 0,0001 gr. de sensibilidad Las campanas de flujo laminar permiten realizar el ensayo microbiológico en un ambiente con menores riesgos de contaminación (Ver figura 4.32), al tener una ligera sobrepresión que evita el paso de atmósfera externa. Pueden estar equipadas de lámparas ultravioleta para esterilizar previamente el ambiente de trabajo. Figura 4.32. Campana de flujo laminar con material de ensayo microbiológico Figura 4.33. Cápsulas petri del ensayo en blanco y con tapones, de hongos filamentosos y levaduras k) Tensión de rotura por torsión. Este parámetro es específico para los tapones de vinos espumosos, debido a que durante su extracción son sometidos, en la parte de mango que queda fuera del gollete de la botella, a una torsión que, en principio, deben ser capaces de soportar sin partirse. De esta forma se evidencia la fortaleza en la unión de las partículas de granulado que forman el mango. , Los resultados se dan en daN/cm2. La fórmula a aplicar es: T = (16 x M) / (&Mac185; x D3) Donde: o T es la tensión de rotura en daNIcM2. El equipo necesario para efectuar este ensayo es: o Máquina para la medida del momento torsor, provista de mordazas. Sensibilidad 0,1 daN x cm. l) Desaglomeración. Este ensayo, específico para los tapones aglomerados, pretende evidenciar la consistencia de las uniones de las partículas de granulado mediante su exposición a una situación agresiva, como es el mantenimiento de los mismos en agua hirviendo durante 30 minutos. El resultado consiste en indicar si desaglomeran o no desaglomeran tras un examen visual. La desaglomeración se produce cuando existe separación sustancial de partículas de granulado o se evidencian grietas claras en al tapón. El equipo necesario para el ensayo consta de: o Erlenmeyer resistente al fuego con capacidad para contener el agua y los tapones, u otro recipiente. m) Longitud y ángulo del bisel. La determinación de esta característica se realiza en los tapones para vinos espumosos, pero puede aplicarse a todos aquéllos que hayan sido biselados para facilitar su utilización. La longitud del bisel se expresa en mm. El ángulo del bisel se expresa en grados sexagesimales (el ángulo recto tiene 90 grados sexagesimales) El equipo para determinar estos parámetros es: oPie de rey, sensibilidad 0,01 mm. (Ver figura 4.21). La longitud del bisel viene dada por: L = [(D – d)2 /4)+ (H - h)2]1/2 El ángulo del bisel viene dado por: Ángulo = arctan [(D - d) /2 (H - h)] Donde: o L es la longitud del bisel, en mm. Figura 4.34. Determinaciones para calcular el bisel de los tapones n) Grosor de los discos. La determinación del grosor de los discos se realiza con pie de rey de 0.01 mm. de sensibilidad. Deben realizarse dos determinaciones sobre los mismos discos formando entre ellas un ángulo aproximado de 180º. El grosor viene dado por la media de las dos determinaciones efectuadas. En la siguiente tabla se recogen los ensayos más característicos que se realizan en los tapones de corcho, así como las especificaciones o valores entre los que deben estar sus resultados, para garantizarnos un buen comportamiento en su función de tapamiento.
5. Otros ensayos.
o Nivel de los residuos oxidantes en tapones que han sido lavados. Las propuestas para estas evaluaciones van desde valoraciones por métodos de oxidación-reducción (Norma portuguesa 4296, para determinar cualitativamente residuos oxidantes), hasta métodos de análisis instrumental para residuos de tricioroanisoles y clorofenoles (cromatografía de gases y espectrometría de masas), así como procedimientos de análisis sensorial como el test Barangé. |
||||||||||||||||||||||||||||||||||||||||||||||||||||||||||||||||||||||||||||||||||||||||||||||||||||||||||||||||||||||||||||||||||||||||||||||||||||||||||||||||||||||||||||||||||||||||||||||||||||||||||||||||||||||||